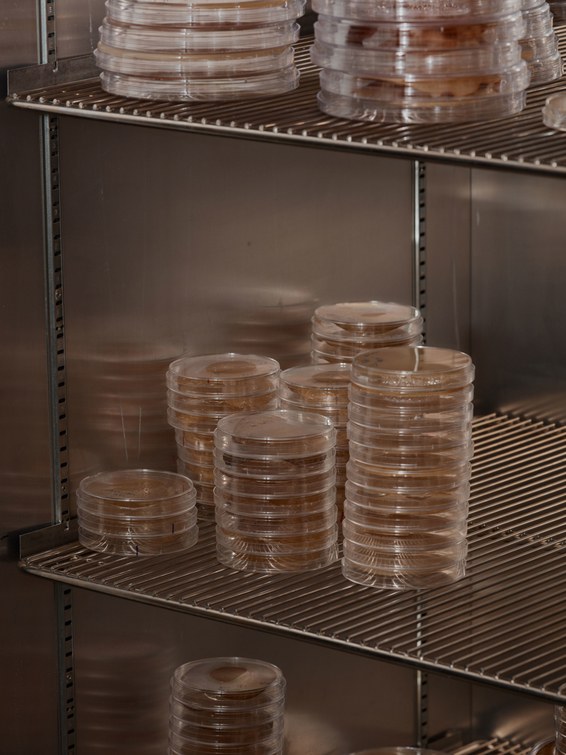
0378_12-27-2017_Sean-Brady(1).jpg

HOW DIRT COULD SAVE HUMANITY FROM AN INFECTIOUS APOCALYPSE
NOBODY SCOURS CENTRAL Park looking for drugs quite the way Sean Brady does. On a sweltering Thursday, he hops out of a yellow cab, crosses Fifth Avenue, and scurries up a dirt path. Around us, the penetrating churn of a helicopter and the honk of car horns filter through the trees. Brady, a fast-talking chemist in his late 40s who sports a graying buzz cut and rimless glasses, has a wry, self-deprecating humor that belies the single-minded determination of his quest. He walks along restlessly. Near the lake, we head up a rock slope and into a secluded area. Brady bends over and picks up a pinch of dusty soil. “Out of that bit of soil,” he says, “you can get enough to do DNA analysis.” He holds it in his fingertips momentarily, and then tosses it. Bits of glassy silica glisten in the sunlight.
Brady is creating drugs from dirt. He’s certain that the world’s topsoils contain incredible, practically inexhaustible reservoirs of undiscovered antibiotics, the chemical weapons bacteria use to fend off other microorganisms. He’s not alone in this thinking, but the problem is that the vast majority of bacteria cannot be grown in the lab—a necessary step in cultivating antibiotics.
Brady has found a way around this roadblock, which opens the door to all those untapped bacteria that live in dirt. By cloning DNA out of a kind of bacteria-laden mud soup, and reinstalling these foreign gene sequences into microorganisms that can be grown in the lab, he’s devised a method for discovering antibiotics that could soon treat infectious diseases and fight drug-resistant superbugs. In early 2016, Brady launched a company called Lodo Therapeutics (lodo means mud in Spanish and Portuguese) to scale up production and ultimately help humanity outrun infectious diseases nipping at our heels. Some colleagues call his approach “a walk in the park.” Indeed, his lab recently dispatched two groups of student volunteers to collect bags full of dirt at 275 locations around New York City.
We’re retracing their path back toward his lab, our shoes crunching down on potential cures for nearly any ailment imaginable. “It’s pretty amazing, right?” Brady says, drawing his words out. “Right here we can find all … the … drugs … in … the world. Pretty cool, I must say.”
At exactly the same time Brady and I are walking around Central Park, a 70-year-old woman arrives at a hospital in Reno, Nevada, with an infection no doctor can treat. The woman had fallen during a trip to India, and a pocket of fluid developed near her hip. She flew back to the US, and then, two weeks later, she was dead. The Centers for Disease Control and Prevention reports that the organism responsible for her death could evade 26 antibiotic drugs. The culprit, pan-resistant Klebsiella pneumoniae, is not the only superbug overpowering humanity’s defenses; it is part of a family known as carbapenem-resistant Enterobacteriaceae. The carpabenems are drugs of last resort, and the CDC considers organisms that evade these antibiotics to be nightmare bacteria.
One problem with antibiotic resistance is that, for most people, it remains abstract—right now its lethal impact is relatively small. Few of us have lost loved ones—yet. (The headline-grabbing methicillin-resistant Staphylococcus aureus, or MRSA, kills 20,000 people a year in the US, compared to the 600,000 who succumb to cancer.) So it’s difficult to envision a future that resembles the pre-antibiotic past—an era of untreatable staph, strep, tuberculosis, leprosy, pneumonia, cholera, diphtheria, scarlet and puerperal fevers, dysentery, typhoid, meningitis, gas gangrene, and gonorrhea.
But that’s the future we are headed for. The routine use of antibiotics and the reckless misuse in humans and animals accelerates resistance: We’re rewinding to a world where death begins in childbirth, where premature babies die, where newborns go blind from gonorrhea. Routine injuries become life-threatening infections. You could lose a limb, or your life, from a careless slip with a paring knife or an accidental fall in India. The risks of organ transplants and medical implants would outweigh any potential benefit. Go in for routine dental surgery and end up in a body bag. Explosive viral epidemics, such as the flu, prove especially lethal when they tag team with bacterial infections like strep. This is not the coming plague. It’s already upon us, and it spells the end of medicine as we know it. And that’s why Brady’s quest to revitalize antibiotic discovery is so crucial.

source
0323_12-27-2017_Sean-Brady.jpg
.jpg)
sourch
SINCE 1939, WHEN René Dubos, a researcher at Rockefeller University, smeared dirt across a Petri plate and isolated the antibiotic gramicidin, the search for antibiotics has largely been culture dependent: It’s limited to the finite percentage of bacteria and fungi that grow in the laboratory. If the chance of finding a new antibiotic in a random soil screen was once one in 20,000, by some estimates the odds have dwindled to less than one in a billion. All the easy ones have already been found.
Historically, it’s a search riddled with accidental discoveries. The fungal strain that was used to manufacture penicillin turned up on a moldy cantaloupe; quinolones emerged from a bad batch of quinine; microbiologists first isolated bacitracin, a key ingredient in Neosporin ointment, from an infected wound of a girl who had been hit by a truck. Other antibiotics turned up in wild, far-flung corners of the globe: Cephalosporin came from a sewage pipe in Sardinia; erythromycin, the Philippines; vancomycin, Borneo; rifampicin, the French Riviera; rapamycin, Easter Island. By persuading the right microbes to grow under the right condition, we unearthed medicinal chemistry that beat back our own microscopic enemies. But despite technological advances in robotics and chemical synthesis, researchers kept rediscovering many of the same easy-to-isolate antibiotics, earning the old-school method a derisive nickname: “grind and find.”
That’s why Brady and others turned to metagenomics—the study of all the genetic information extracted from a given environment. The technique originated in the late 1980s, when microbiologists began cloning DNA directly out of seawater and soil. Extracted and cut up into chunks, this environmental DNA could be maintained in the lab by inserting the foreign gene fragments into bacteria such as E. coli (thereby creating what’s known as an artificial chromosome). These clones contained libraries, a living repository for all the genomes of all the microbes found in a particular environment.
Using high-throughput DNA sequencing, scientists then searched these libraries and their census turned up such astronomical biodiversity that they began adding new branches to the tree of life. By some estimates, the earth harbors more than a trillion individual microbe species. A single gram of soil alone can contain 3,000 bacterial species, each with an average of four million base-pairs of DNA spooled around a single circular chromosome. The next steps followed a simple logic: Find novel genetic diversity, and you’ll inevitably turn up new chemical diversity.
In 1998, Brady was part of a team that laid out a straightforward strategy for isolating DNA from the dirt-dwelling bugs, by mixing mud with detergent, inserting gene fragments into E. coli, and, finally, plating clones into Petri dishes to see what molecules they produced. By the time Brady set up his own lab at Rockefeller University, in 2006, he’d created a handful of novel compounds. Some had anticancer properties; others acted as antibiotics. He had studied the DNA plucked out of a tank filled with bromeliads in Costa Rica and produced palmitoylputrescine, an antibiotic that was effective in vitro against a resistant form of B. subtilis bacteria. Brady came to realize that he did not need to trek to some pristine or remote ecosystem to explore the world’s biodiversity. The requisite material for building new drugs could be found much closer to home.
All the while, Brady watched as the pace of antibiotic resistance eclipsed the faltering pace of discovery. Much of that has to do with the pharmaceutical industry’s bottom line. Taking a novel drug through clinical testing and human trials takes, on average, about 10 years and several billion dollars. At best one in five new drugs succeeds, and so the financial rewards are mismatched with the immense value antibiotics provide to society. Some of this comes down to the drug’s nature and activity: The more we use antibiotics, the less effective they become; the more selective pressures we apply, the more likely resistant strains will emerge.
And so antibiotics used to treat the deadliest pathogens are kept as a last resort when all else fails, such as the carbapenems. Gravely ill patients taking last-line antibiotics can end up dead or they can end up cured; either way, they’re not repeat customers, which over the long term adds up to a negligible or negative return on investment. Waiting until the market for these life-saving antibiotics reaches critical mass for profitability is a recipe for catastrophe. As Richard Ebright, a researcher at Rutgers, explains, “Unfortunately, at that point, you will have 10 million people dying for the next decade while you’re rebooting the system.” By some estimates, antibiotic drugs make up less than 1.5 percent of compounds in development. According to the Pew Charitable Trust, fewer than half the drugs being developed address the high-priority pathogens, including drug-resistant forms of TB and staph. These are world’s deadliest diseases, and they are at the top of Brady’s list of targets.
THREE YEARS AGO, Brady got a cold call from the Bill and Melinda Gates Foundation. On the line was Trevor Mundel, a former pharmaceutical executive who’s now the organization’s president of global health. The foundation wants to find drugs that treat TB, a disease that kills two million people a year, rivaling AIDS as the leading cause of death worldwide. TB used to be treatable with a triple-antibiotic cocktail that included rifampicin. Rif, as it’s known, was discovered almost 50 years ago, and over time the bacterium causing TB has developed a resistance. Intrigued by Brady’s “science fiction approach,” Mundel asked Brady if he could come up with a couple of new molecules that would be effective against TB.
Brady is focused on finding analogs, which are slight tweaks or modifications to the chemical structure of drugs that already exist. (Think of it as a variation on a familiar theme—a riff on rif.) Searching through metagenomic libraries Brady created from soils, he could see the different ways nature evolved to make rif. He looked for a familiar pattern: the gene clusters that created something similar to the original rif molecule, only with a chemical bond in a slightly different place, or an additional atom.
Find these analogs, and we’d once again be able to outwit Mycobacterium tuberculosis and effectively treat TB. Within six months, Brady convincingly demonstrated that he could find rif analogs as well as variants of the antibiotics vancomycin and daptomycin, which have also become increasingly ineffective because of bacterial resistance. The foundation set up a lunch meeting for him with Bill Gates, and the following January, with $17 million in venture capital from the Gates Foundation and Seattle life sciences investment outfit Accelerator, Brady founded his company.
On a bright clear day in September, Brady brings me up to Lodo’s office on the eighth floor of a glass-fronted tower at the Alexandria Center for Life Science. We pass a small room with a freezer and two shaker incubators the size of pizza ovens that warm flasks filled with bacteria, and he leads me into a pristine lab overlooking Bellevue Hospital. Ten people work at Lodo. Eleven if you count the robot. The automated Perkin-Elmer workstation, large enough to crawl inside, speeds up the discovery process by searching metagenomic libraries and plucking out the clones containing a target sequence, almost like a precision mechanical claw. Work that once took technicians and post-docs six months to a year to complete can now be accomplished in a week. That speed is already paying off. A chart on the wall lists at least 30 potential antibiotics Lodo is in the process of generating and characterizing this week alone. Brady recently identified one that cured MRSA in mice.
Brady circles the robot, hands in his pockets. The machine has been acting up. Its arms stand motionless. The process begins with soil, which arrives from donors and volunteers. Brady’s team then reduces dirt to its constituent DNA and clones the gene fragments from unculturable organisms into bacteria, which are stored in rectangular well plates the size of a brick—the so-called libraries. The challenging part is searching for a target, since all the genetic fragments are jumbled up, almost as if someone’s haphazardly tossed thousands of jigsaw pieces into a box. “So we have this very big mixture,” Brady says, “and it starts with 10 million clones and we divide it into a subset of pools..............





Source
Plagiarism is the copying & pasting of others work without giving credit to the original author or artist. Plagiarized posts are considered spam.
Spam is discouraged by the community, and may result in action from the cheetah bot.
More information and tips on sharing content.
If you believe this comment is in error, please contact us in #disputes on Discord
Hi! I am a robot. I just upvoted you! I found similar content that readers might be interested in:
https://www.wired.com/story/how-dirt-could-save-humanity-from-an-infectious-apocalypse/
SORRY robot